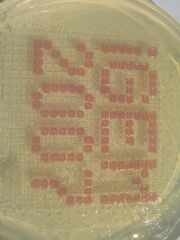

Uploads by KMagic246
From OpenWetWare
Jump to navigationJump to search
This special page shows all uploaded files.
| Date | Name | Thumbnail | Size | Description |
|---|---|---|---|---|
| 21:53, 30 October 2007 | Harvardigem07finalppt v23.ppt (file) | 3.11 MB | ||
| 20:52, 16 August 2007 | Week9-10.jpg (file) |  |
922 KB | |
| 20:51, 16 August 2007 | Week9-9.jpg (file) |  |
487 KB | |
| 20:51, 16 August 2007 | Week9-8.jpg (file) |  |
483 KB | |
| 20:50, 16 August 2007 | Week9-7.jpg (file) |  |
685 KB | |
| 20:50, 16 August 2007 | Week9-6.jpg (file) | |
702 KB | |
| 20:49, 16 August 2007 | Week9-5.jpg (file) |  |
659 KB | |
| 20:48, 16 August 2007 | Week9-4.jpg (file) |  |
562 KB | |
| 20:48, 16 August 2007 | Week9-3.jpg (file) |  |
1.16 MB | |
| 20:47, 16 August 2007 | Week9-2.jpg (file) |  |
1.18 MB | |
| 20:47, 16 August 2007 | Week9-1.jpg (file) |  |
1.17 MB | |
| 20:45, 16 August 2007 | Week6-7.jpg (file) |  |
298 KB | |
| 20:44, 16 August 2007 | Week6-6.jpg (file) |  |
241 KB | |
| 20:44, 16 August 2007 | Week6-5.jpg (file) |  |
328 KB | |
| 20:43, 16 August 2007 | Week6-4.jpg (file) |  |
334 KB | |
| 20:43, 16 August 2007 | Week6-3.jpg (file) |  |
296 KB | |
| 20:43, 16 August 2007 | Week6-2.jpg (file) |  |
281 KB | |
| 20:41, 16 August 2007 | Week6-1.jpg (file) |  |
308 KB | |
| 14:37, 30 July 2007 | KevinMikeGel.jpg (file) |  |
147 KB | |
| 14:34, 30 July 2007 | KevinMikePCR.jpg (file) |  |
147 KB | |
| 16:38, 26 July 2007 | IGEM Lab Tour.wmv (file) | 5.11 MB | ||
| 15:05, 26 July 2007 | MVI 0152.avi (file) | 5.35 MB | ||
| 14:55, 26 July 2007 | The Fly.MPG (file) | 15.11 MB | ||
| 18:17, 16 July 2007 | Munchbacteria copy.jpg (file) |  |
265 KB | |
| 17:51, 16 July 2007 | Face of biology.jpg (file) |  |
538 KB | |
| 18:46, 10 July 2007 | ThumbWiki.png (file) |  |
38 KB | |
| 18:39, 10 July 2007 | Webpage.png (file) |  |
104 KB | |
| 15:34, 9 July 2007 | The Harvard iGEM Team Wiki etc Presentation.ppt (file) | 3.69 MB | ||
| 16:52, 28 June 2007 | IMG 0115.JPG (file) |  |
232 KB | |
| 16:49, 28 June 2007 | IMG 0154.JPG (file) |  |
429 KB | |
| 16:49, 28 June 2007 | IMG 0151.JPG (file) |  |
365 KB | |
| 16:48, 28 June 2007 | IMG 0150.JPG (file) |  |
331 KB | |
| 16:46, 28 June 2007 | IMG 0147.JPG (file) |  |
758 KB | |
| 16:46, 28 June 2007 | IMG 0146.JPG (file) |  |
716 KB | |
| 16:44, 28 June 2007 | IMG 0120.JPG (file) |  |
195 KB | |
| 16:43, 28 June 2007 | IMG 0117.JPG (file) |  |
328 KB | |
| 16:43, 28 June 2007 | IMG 0116.JPG (file) |  |
329 KB | |
| 16:41, 28 June 2007 | IMG 0113.JPG (file) |  |
270 KB | |
| 16:41, 28 June 2007 | IMG 0112.JPG (file) |  |
253 KB | |
| 16:40, 28 June 2007 | IMG 0107.JPG (file) |  |
333 KB | |
| 16:39, 28 June 2007 | IMG 0106.JPG (file) |  |
350 KB | |
| 16:36, 28 June 2007 | IMG 0167.JPG (file) |  |
271 KB | |
| 16:35, 28 June 2007 | IMG 0163.JPG (file) |  |
346 KB | |
| 16:35, 28 June 2007 | IMG 0161.JPG (file) |  |
447 KB | |
| 16:34, 28 June 2007 | IMG 0160.JPG (file) |  |
255 KB | |
| 16:34, 28 June 2007 | IMG 0159.JPG (file) |  |
563 KB | |
| 16:34, 28 June 2007 | IMG 0157.JPG (file) |  |
422 KB | |
| 16:33, 28 June 2007 | IMG 0156.JPG (file) |  |
300 KB | |
| 14:50, 22 June 2007 | Strong iGEM 6 19 07.ppt (file) | 978 KB | ||
| 14:49, 22 June 2007 | Strong iGEM 6 18 07.ppt (file) | 1.63 MB |